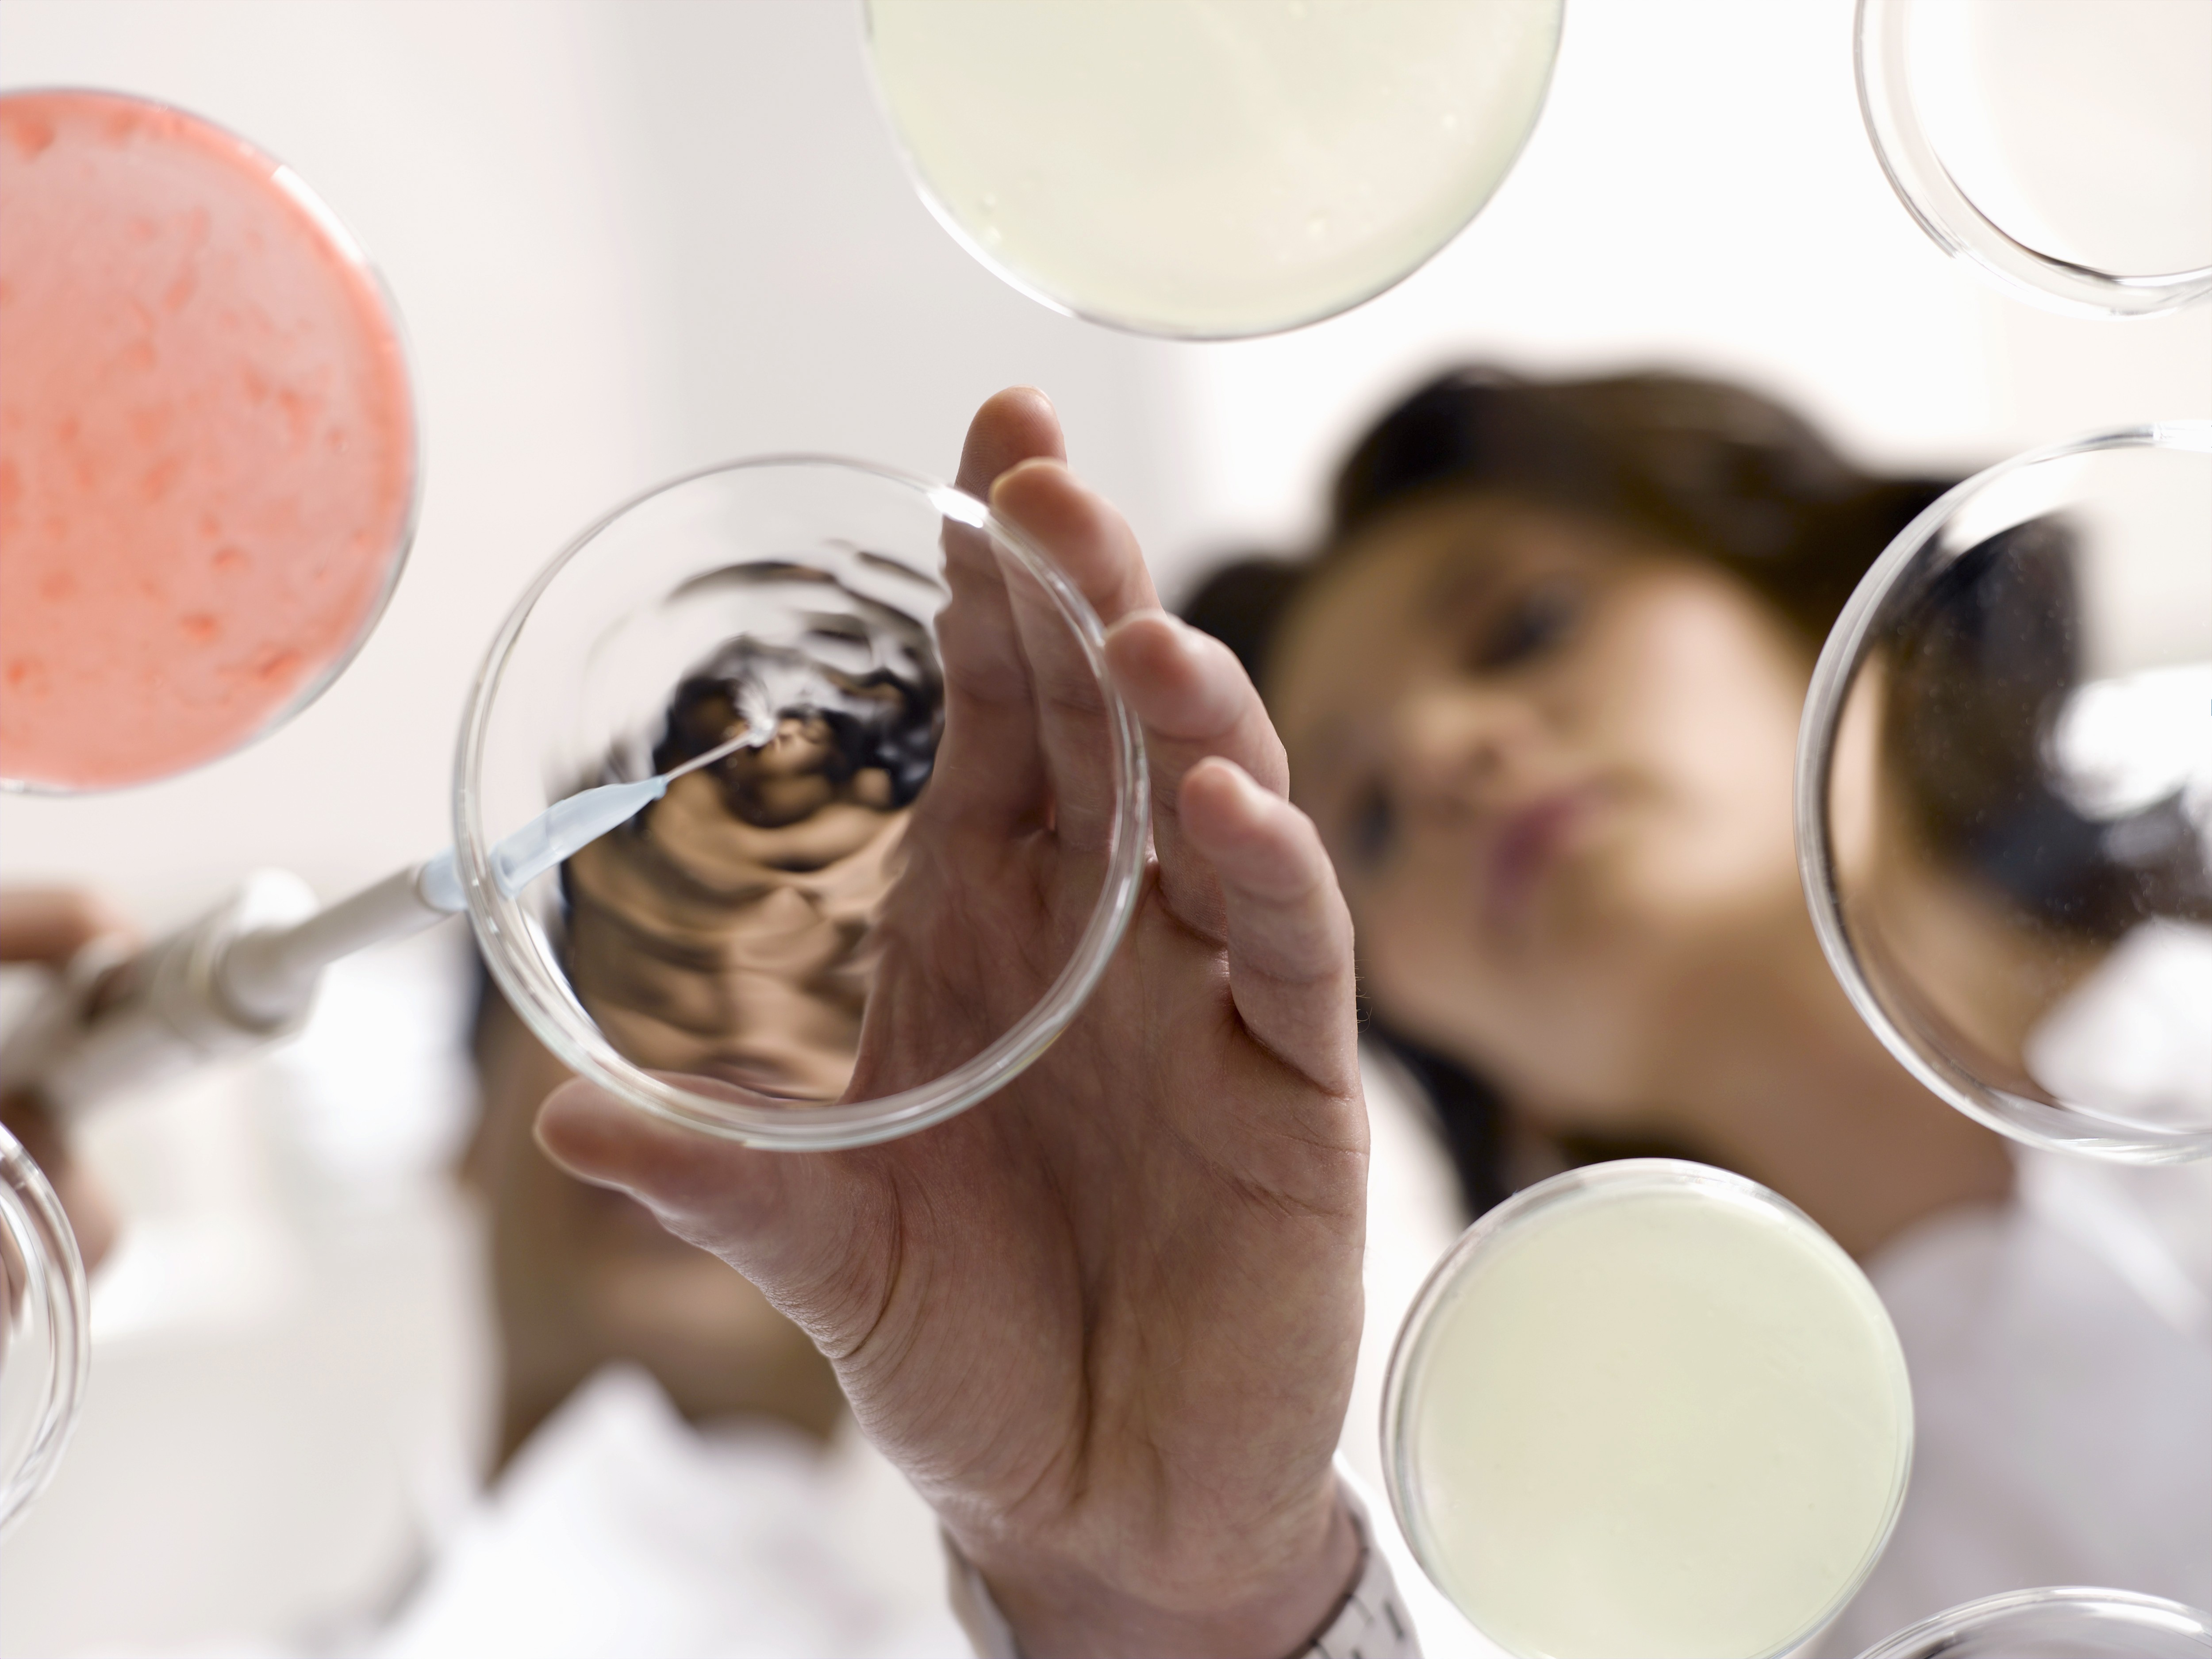
The image featured in the middle of the about us page

Detergents
Detergents
lab
lab
Pharmilabprovidestechnicalandregulatorysupportinthedevelopmentandmarketplacementofdetergents,ensuringcompliancewithRegulation(EC)No.648/2004andotherapplicablerequirements.
Pharmilabisahighlyexperiencedproviderofcompletesolutionsforthedevelopment,regulation,andmarketplacementofcosmeticproducts,guaranteeinglegalcomplianceandqualityateverystep.
Pharmilabprovidestechnicalandregulatorysupportinthedevelopmentandmarketplacementofdetergents,ensuringcompliancewithRegulation(EC)No.648/2004andotherapplicablerequirements.
Weoverseetheentireprocess,fromformulationandlabellingtothepreparationoftechnicalandsafetydatasheets,ensuringproductsthataresafe,effective,andlegallycompliant.
Fromformulationtolabelling,includingsafetyassessmentandregulatorysubmissions,weoverseeeverystepwithscientificrigorandup-to-dateindustryknowledge.
Weoverseetheentireprocess,fromformulationandlabellingtothepreparationoftechnicalandsafetydatasheets,ensuringproductsthataresafe,effective,andlegallycompliant.


Microbiological tests
Microbiology and Physicochemicals
Microbiological
tests
Many products are susceptible to pathogen contamination during production, packaging, or consumer use, posing risks to health. To ensure safety and compliance with Good Manufacturing Practices, products should undergo microbiological testing. This may include counting mesophilic aerobic bacteria, moulds, and yeasts, as well as detecting specific pathogens like Escherichia coli, Staphylococcus aureus, Pseudomonas aeruginosa, and Candida albicans.
Many products are susceptible to pathogen contamination during production, packaging, or consumer use, posing risks to health. To ensure safety and compliance with Good Manufacturing Practices, products should undergo microbiological testing. This may include counting mesophilic aerobic bacteria, moulds, and yeasts, as well as detecting specific pathogens like Escherichia coli, Staphylococcus aureus, Pseudomonas aeruginosa, and Candida albicans.
Many products are susceptible to pathogen contamination during production, packaging, or consumer use, posing risks to health. To ensure safety and compliance with Good Manufacturing Practices, products should undergo microbiological testing. This may include counting mesophilic aerobic bacteria, moulds, and yeasts, as well as detecting specific pathogens like Escherichia coli, Staphylococcus aureus, Pseudomonas aeruginosa, and Candida albicans.
Stability Testing
Mutual Recognition in the EU
Stability studies evaluate a product's ability to maintain its physical, chemical, and microbiological quality, as well as its safety and functionality, over time. These tests are essential for determining shelf life, optimizing packaging and formulations, and defining storage conditions.
Stability studies evaluate a product's ability to maintain its physical, chemical, and microbiological quality, as well as its safety and functionality, over time. These tests are essential for determining shelf life, optimizing packaging and formulations, and defining storage conditions.
Stability studies evaluate a product's ability to maintain its physical, chemical, and microbiological quality, as well as its safety and functionality, over time. These tests are essential for determining shelf life, optimizing packaging and formulations, and defining storage conditions.

Physico-chemical tests
Request for assignment of a National Product Code (CNP)
Physico-chemical tests are used to confirm batch uniformity and ensure product safety. Pharmilab conducts a variety of these tests, including assessments for:
pH, viscosity, density, Dry matter/water content
Active matter content
Anionic / non-ionic / cationic surfactants, Total surfactant content
Total alkalinity or acidity
Salt content (e.g. sodium chloride, sulfates)
Phosphate content
Physico-chemical tests are used to confirm batch uniformity and ensure product safety. Pharmilab conducts a variety of these tests, including assessments for:
pH, viscosity, density, Dry matter/water content
Active matter content
Anionic / non-ionic / cationic surfactants, Total surfactant content
Total alkalinity or acidity
Salt content (e.g. sodium chloride, sulfates)
Phosphate content
Physico-chemical tests are used to confirm batch uniformity and ensure product safety. Pharmilab conducts a variety of these tests, including assessments for:
pH, viscosity, density, Dry matter/water content
Active matter content
Anionic / non-ionic / cationic surfactants, Total surfactant content
Total alkalinity or acidity
Salt content (e.g. sodium chloride, sulfates)
Phosphate content

Performance Testing
Nutritional and Health Claims
Pharmilab (accredited to NP EN ISO/IEC 17025:2018) conducts specific performance protocols to evaluate and compare the efficacy of various products. Their testing capabilities cover a wide range of categories, including cosmetics, detergents (laundry and dishwashing), hygiene products, disinfectants, tissue paper, general cleaning agents, and candles/home fragrances.
Pharmilab (accredited to NP EN ISO/IEC 17025:2018) conducts specific performance protocols to evaluate and compare the efficacy of various products. Their testing capabilities cover a wide range of categories, including cosmetics, detergents(laundry and dishwashing), hygiene products, disinfectants, tissue paper, general cleaning agents, and candles/home fragrances.
Pharmilab (accredited to NP EN ISO/IEC 17025:2018) conducts specific performance protocols to evaluate and compare the efficacy of various products. Their testing capabilities cover a wide range of categories, including cosmetics, detergents (laundry and dishwashing), hygiene products, disinfectants, tissue paper, general cleaning agents, and candles/home fragrances.
Conquer the world
with your brand
Fill out the form today and experience expert services

Conquer the world
with your brand
Fill out the form today and experience expert services

Conquer the world
with your brand
Fill out the form today and experience expert services
